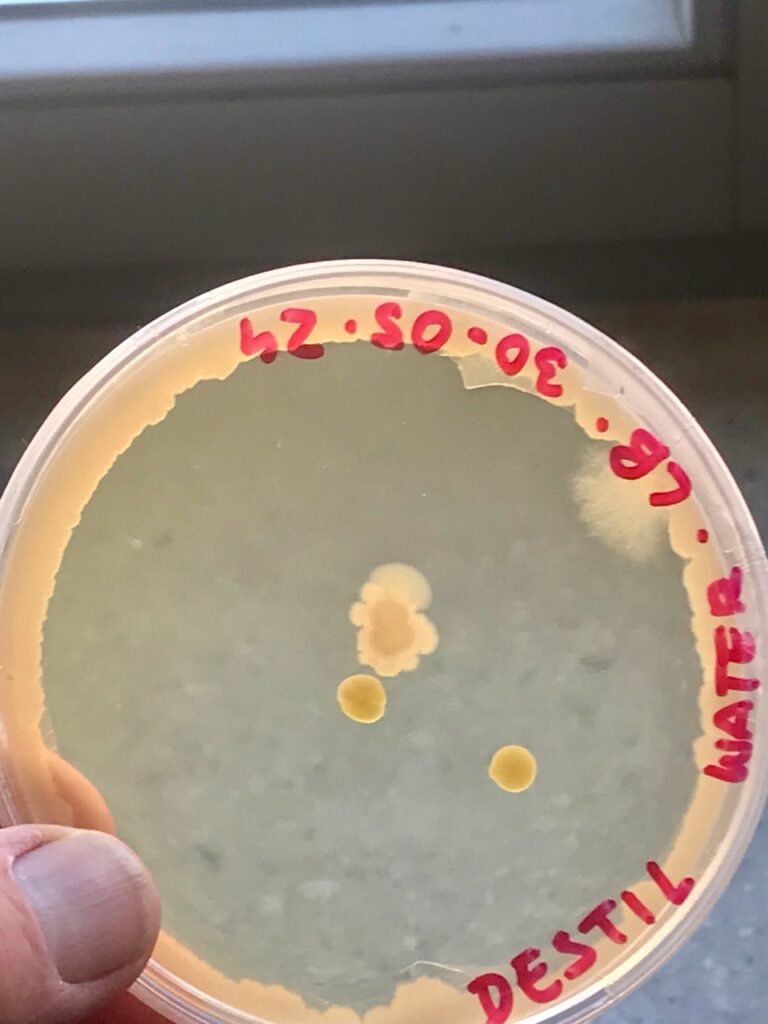
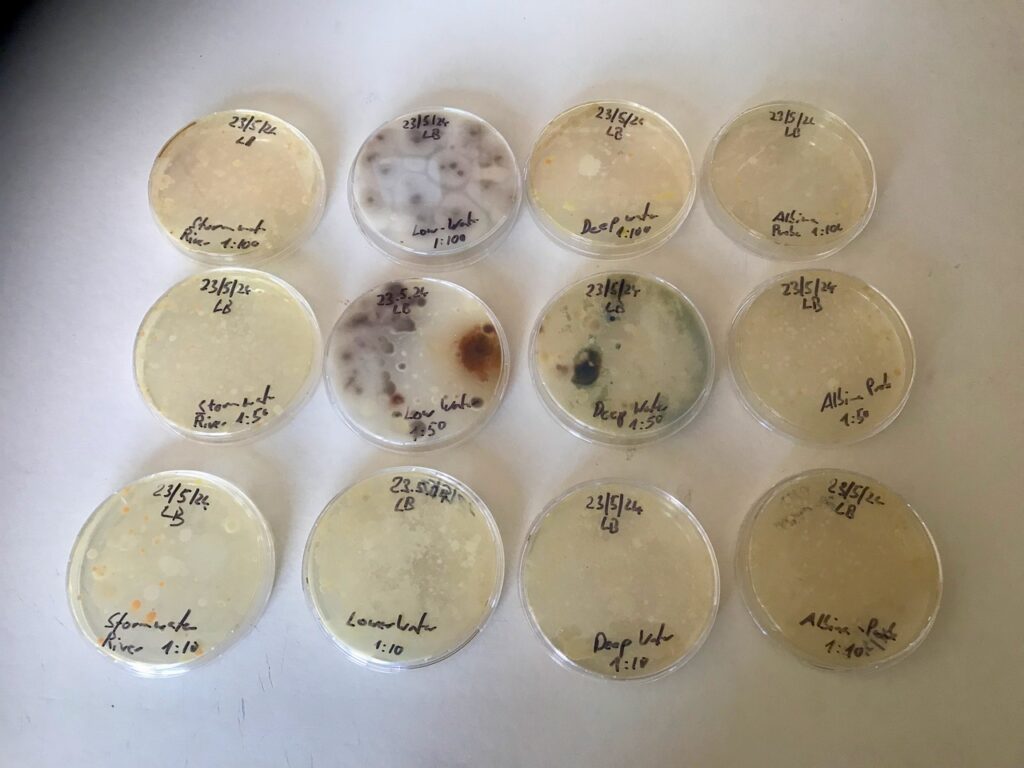
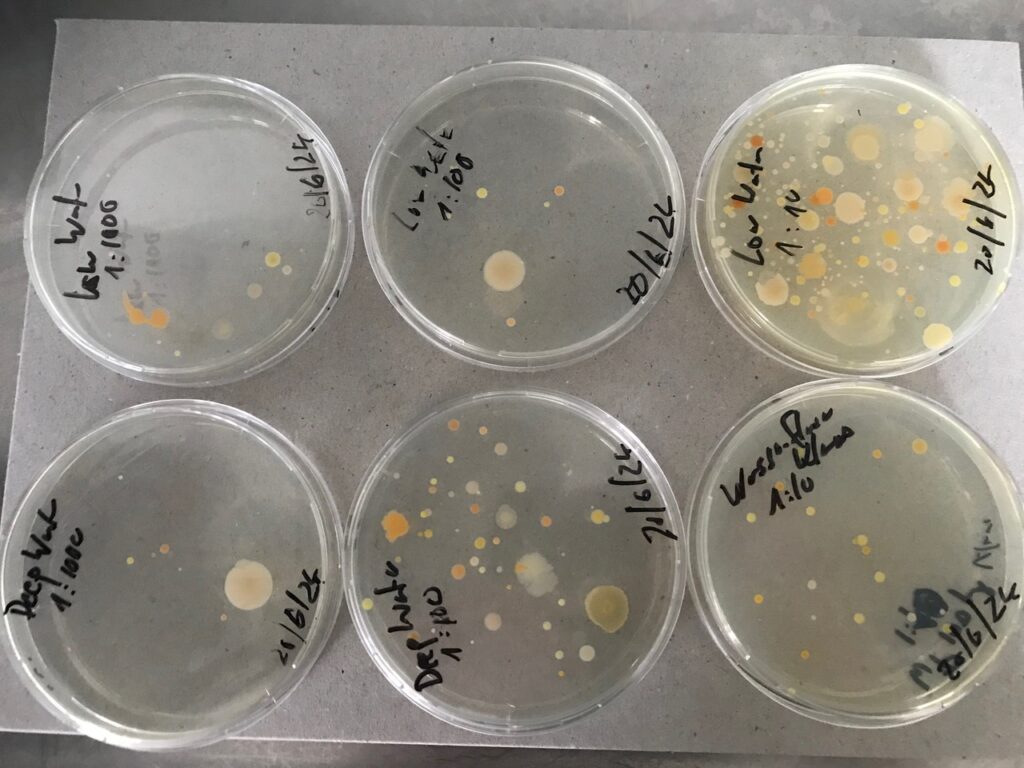
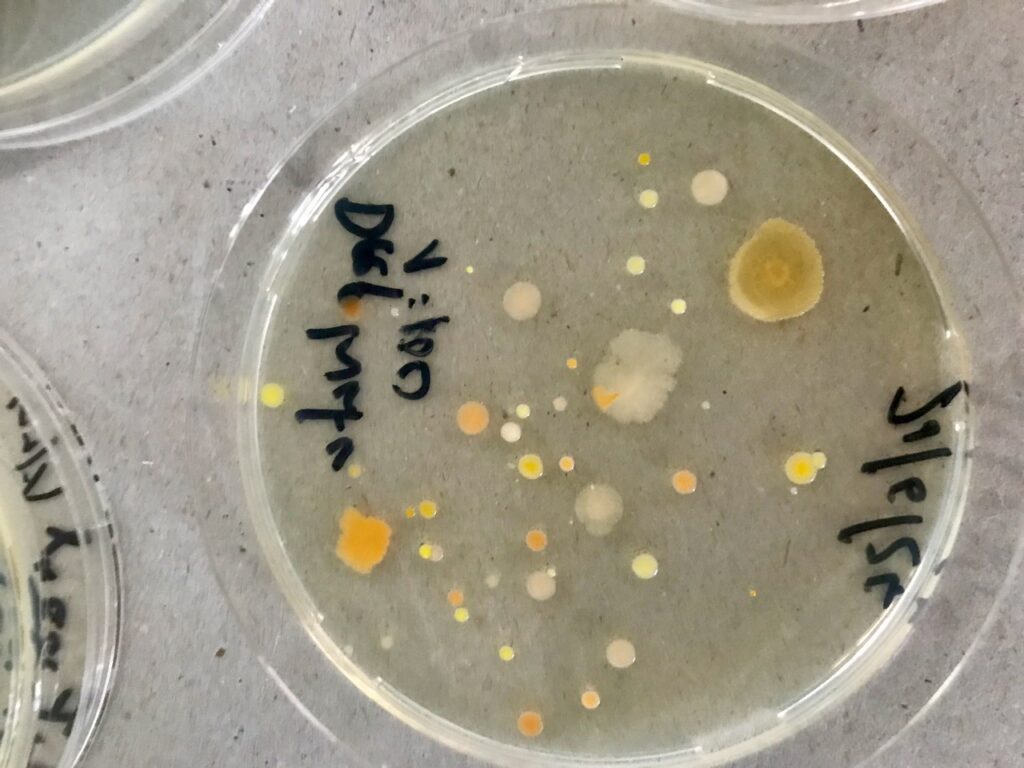

Klaus Fritze Herbst
We could examine the pond microscopically, but would probably be looking for needles in a haystack at 1000x magnification. Our strategy will therefore be to try to multiply the microbes in culture and make them visible through their diversity.
Culture media are prepared and cooked according to sophisticated rules. The culture or nutrient media are habitats that favor the growth of one type of organism or another, and provide poor conditions for others following Darwin’s rule of “struggle for life“. Many volumes of instructions and recipes enable a species to be isolated from a complex environment by strong growth or suppression. The process often results in what is known as a pure culture, though achieving this typically requires many rounds of experimentation and dilution. Experienced microbiologists are skilled in this practice, devising a series of sophisticated habitats to trace and cultivate entirely unknown organisms from across the globe.
Related Media